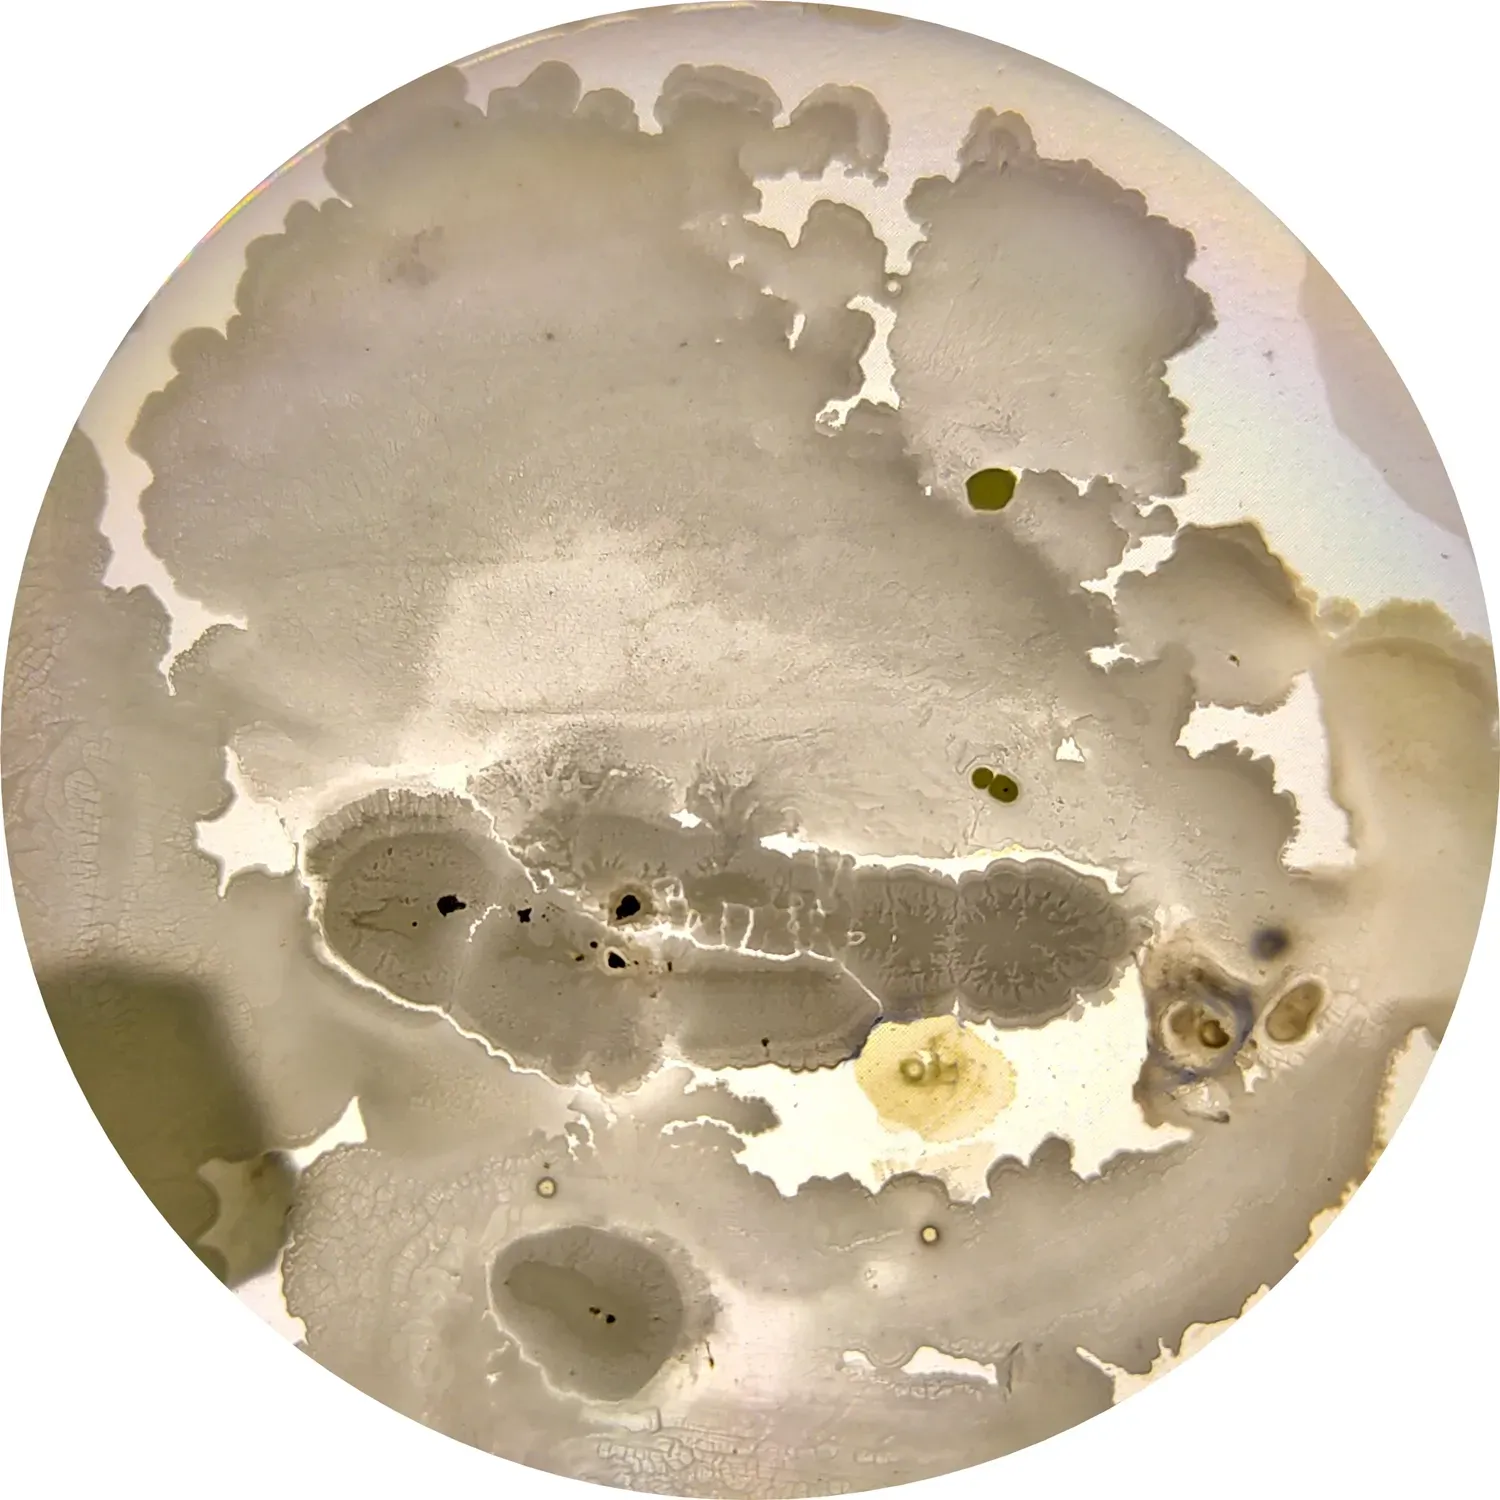
A Newly Discovered Organism Reveals Ancient Secrets (Image Credits: Wikimedia)

You’ve probably wondered at some point where we all came from. Not just humanity, but life itself. How did the first living thing emerge from a lifeless planet roughly four and a half billion years old? That question has captivated curious minds for centuries, from philosophers to modern scientists working in laboratories and diving into the deepest ocean trenches.
The search for answers has never been more exciting. Recent discoveries are pulling back the curtain on what might have happened in Earth’s ancient past, and honestly, some of these findings challenge everything researchers thought they knew. Let’s dive into what scientists are uncovering about the spark that ignited life on our planet.
Complex Life Evolved Much Earlier Than Anyone Expected

Scientists have discovered that complex life began evolving much earlier than traditional models suggested, with crucial cellular features emerging in ancient anoxic oceans long before oxygen became a major part of Earth’s atmosphere. Think about that for a moment. The old assumption was that plentiful oxygen had to come first before anything sophisticated could develop.
Complex life began taking shape in Earth’s oxygen-free oceans nearly a billion years earlier than previously believed, and it formed over a far longer period than researchers previously understood. This isn’t just a minor adjustment to the timeline. It completely reshapes how you should picture early Earth and the conditions that allowed the first organized cells to appear. The traditional story might have gotten the order wrong.
The RNA World May Hold the Key to Everything

Here’s where things get truly fascinating. Researchers chemically linked life’s amino acids to RNA in conditions that could have occurred on the early Earth, an achievement that has eluded scientists since the early 1970s. RNA is that fascinating molecule that can both store genetic information and catalyze chemical reactions, unlike its more famous cousin DNA.
The team showed that RNA can become chemically linked to amino acids, and these small molecules build proteins, with the linkage occurring under mild conditions in water. What makes this so groundbreaking? It demonstrates a plausible pathway for how the machinery of life could have bootstrapped itself into existence without needing the complex cellular equipment that exists today. The ingredients were simpler than you might imagine.
Hydrothermal Vents Might Be Life’s Ancient Cradle

Picture yourself at the bottom of the ocean where scalding water bursts from cracks in the seafloor, mixing minerals and chemicals in a turbulent dance. Researchers recreated the spontaneous formation of fatty acid molecules by combining hydrogen-rich fluids, likely present in ancient alkaline hydrothermal vents, with carbon dioxide-rich water resembling the early ocean, which aligns with the hypothesis that stable fatty acid membranes could have originated in alkaline hydrothermal vents.
For the first time, researchers succeeded at creating self-assembling protocells in an environment similar to that of hydrothermal vents, finding that the heat, alkalinity and salt did not impede the protocell formation but actively favoured it. This completely flips previous experimental results on their head. The harsh conditions that seemed like obstacles actually helped basic cell structures form. Life might prefer the pressure cooker.
Amino Acids Appeared in a Different Order Than Expected

Scientists are making a case for adjusting our understanding of how exactly genes first emerged, with researchers at the University of Arizona suggesting that previous assumptions may reflect biases in our understanding of biotic versus abiotic sources. The conventional wisdom about which amino acids showed up first in the primordial soup needs revision.
One big paradigm shift proposed by this research is the idea that we should rethink the order in which the essential genetic amino acids emerged from the stew of early Earth, with scientists arguing that the current model overemphasizes how often an amino acid appeared in an early life form. Let’s be real, this matters because it changes where scientists should look for signs of emerging life, both on Earth’s ancient past and on other worlds.
Energy Sources Were Hiding in Plain Sight

Under the environmental conditions at deep sea hydrothermal vents, the central biosynthetic reactions of life do not require an external energy source, with these core metabolic reactions releasing energy all by themselves as long as hydrogen and carbon dioxide are in supply. No sunlight required. No lightning strikes necessary. Just chemistry doing its thing in the dark depths.
When researchers calculated the value of Gibbs free energy for biosynthetic reactions under the conditions of hydrogen producing hydrothermal vents, they found that up to nearly all of the chemical reactions that make the building blocks of life release energy. The reactions essentially power themselves. It’s hard to say for sure, but this suggests life didn’t need some dramatic external spark after all.
A Newly Discovered Organism Reveals Ancient Secrets
The discovery of Solarion arienae, a previously unknown unicellular organism, provides new insight into the earliest stages of complex life on Earth. This microscopic creature, invisible to your naked eye, carries genetic signatures from billions of years ago. Finding it is like discovering a living fossil that never went extinct.
By analyzing its genetic and cellular makeup, the research team identified traces of ancient mitochondrial pathways, suggesting that the earliest eukaryotes were far more metabolically versatile than their modern descendants. Your cells today are actually less flexible than their ancient ancestors. Evolution sometimes means specialization rather than increasing complexity.
Harvard Scientists Created Artificial Life-Like Systems

A team of Harvard scientists has brought us closer to an answer by creating artificial cell-like chemical systems that simulate metabolism, reproduction, and evolution. They’re not claiming to have created actual life in a test tube, but they’ve replicated some of life’s essential features in the laboratory. The boundaries between chemistry and biology blur when you watch these systems operate.
This work matters because it tests whether the theoretical pathways from non-living chemicals to living organisms actually work in practice. The experiments don’t just sit on paper as nice ideas. They demonstrate that under the right conditions, the leap from chemistry to life becomes less mysterious and more inevitable.
The Search Extends Beyond Earth

Space missions have found evidence that icy moons of Jupiter and Saturn might also have similarly alkaline hydrothermal vents in their seas. If life emerged from vents on Earth, then Europa and Enceladus become prime candidates for hosting their own origin stories. The universe suddenly feels less lonely when you consider the possibilities.
The implications stretch your imagination. Every discovery about how life began here informs where scientists should look elsewhere. Improvements in understanding could not only allow us to know more of our own story, but also help us search for the beginnings of life elsewhere in the universe. The ancient past and the cosmic future are intimately connected through these discoveries.
Conclusion

The origin of life on Earth remains one of science’s most profound mysteries, yet each discovery brings us closer to understanding that remarkable transition from chemistry to biology. From the depths of ancient oceans to the sophisticated dance of RNA and amino acids, researchers are piecing together a story that’s simultaneously more complex and more elegant than previous generations imagined.
What strikes me most is how these findings challenge assumptions that seemed rock solid just years ago. Life didn’t wait for perfect conditions. It emerged in harsh environments, evolved without abundant oxygen, and powered itself through chemical reactions that required no external spark. The resilience and inevitability of life under the right conditions is both humbling and inspiring.
As scientists continue probing Earth’s most extreme environments and simulating ancient conditions in laboratories, the picture becomes clearer. Life’s origins weren’t a single miraculous moment but rather a gradual, almost inevitable progression once the right chemical ingredients came together. What do you think drove that first spark? The answer might be simpler and stranger than anyone expected.

Jan loves Wildlife and Animals and is one of the founders of Animals Around The Globe. He holds an MSc in Finance & Economics and is a passionate PADI Open Water Diver. His favorite animals are Mountain Gorillas, Tigers, and Great White Sharks. He lived in South Africa, Germany, the USA, Ireland, Italy, China, and Australia. Before AATG, Jan worked for Google, Axel Springer, BMW and others.



